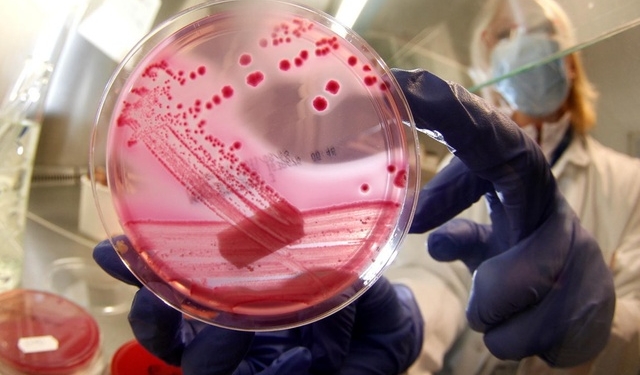
Швейцарские ученые нашли новый класс синтетических антибиотиков

Новые антибиотики препятствуют повышению степени непроницаемости бактериальных мембран, делая даже грамотрицательные бактерии чувствительными к воздействию лекарственных препаратов, что станет, если открытие будет подтверждено клиническими испытаниями на людях, огромным шагом вперед в борьбе с антибиотикорезистентностью.
Об этом пишет swissinfo.
К числу грамотрицательных бактерий относятся, в частности, кишечная палочка (escherichia coli), сальмонеллы (salmonella), легионеллы (legionella) и хламидии (chlamydia trachomatis). Как сообщили на прошлой неделе ученые Цюрихского университета, новый класс открытых ими антибиотиков нашел «общий язык» для коммуникации с элементами, из которых складывается внешняя бактериальная мембрана, в частности, с молекулами класса липидов (фосфолипиды), а также с протеином класса BamA.
В результате воздействия нового класса препаратов мембраны грамотрицательных бактерий теряют свои свойства, и бактерии отмирают. Новый тип антибиотиков назван аббревиатурой «Ompta» от английского «Outer Membrane Protein Targeting Antibiotics». Соответствующая публикация по итогам исследования была опубликована в журнале «Nature». Данный проект был совместным исследованием ученых Университета Цюриха, Высшей технической школы Цюриха (ETH Zürich), Центра Биотехнологий (Biozentrum) в Базеле и фармацевтической компании Polyphor со штаб-квартирой в городе Алльшвиль (Allschwil, кантон Базель-сельский).
Как заявила эта компания, одну из новых субстанций (POL7306) уже в следующем году планируется испытать на людях. Для начала новый антибиотик испытают на здоровых пробандах с тем, чтобы оценить, какие негативные побочные явления препарат может вызывать при воздействии на организм человека. И только после этого антибиотик будет тестироваться на реальных пациентах. Если все подтвердится, то это открытие будет огромным шагом в борьбе с антибиотикорезистентностью.
По данным ВОЗ, основную угрозу сейчас представляют собой грамотрицательные бактерии, способные сохранять невосприимчивость при обработке карбапенемами (класс β-лактамных антибиотиков с широким спектром действий) и цефалоспоринами (класс β-лактамных антибиотиков, в основе химической структуры которых лежит 7-аминоцефалоспорановая кислота).
Такие бактерии сейчас вызывают у людей, например, менингит, заражение крови и очаговые гнойные инфекции. Последним прорывным открытием в этой области стал вывод на рынок еще в 1960-х годах так называемых фторхинолонов (fluoroquinolones) — группы лекарственных веществ, обладающих выраженной противомикробной активностью, широко применяющихся в медицине в качестве антибактериальных лекарственных средств широкого спектра действия.
Новые антибиотики, однако, миру сейчас нужны, как никогда, потому что сопротивляемость колистину, лекарству последнего резерва (антибиотик, продуцируемый некоторыми штаммами бактерии Paenibacillus polymyxa, эффективен пока против большинства грамотрицательных бактерий, хотя токсичен для почек и даже порой нейротоксичен) пока редка, но и она постепенно растёт.
Как сообщало «Інше ТВ», В Африке обнаружили новую супербактерию